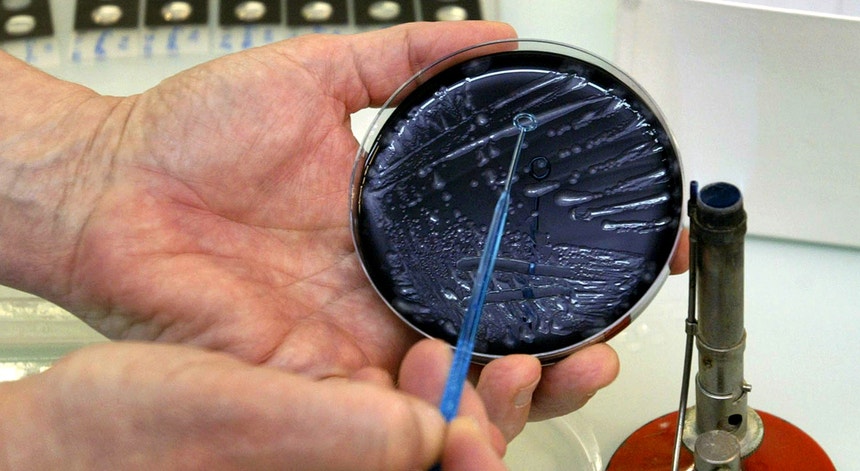

País
Legionella. Um dos doentes infetados está na Unidade de Cuidados Intensivos
A Direção-Geral da Saúde confirma que há seis casos de legionella identificados pelo Hospital de São João, no Porto. Um dos doentes infetados está na Unidade de Cuidados Intensivos.
Foto: Robert Pratta - Reuters